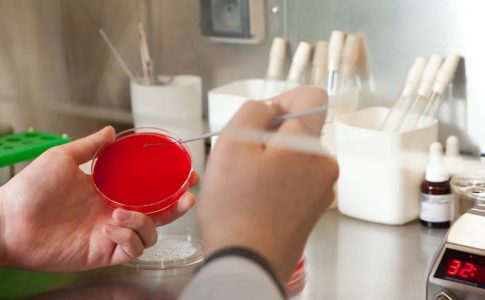

-
Проект «Тополя»
Социальный проект «Тополя» — это платформа, созданная для общения детей и родителей. Существует традиция, когда рождается ребенок в семье, сажают ... -
Ҳоло дер нашудааст!
Мегӯянд, он ҷо ки умед тамом мешавад, афтодаруҳӣ сар боло мекунад. Ҳар он чизе ки инсон ба беҳтар шуданаш бовар ... -
Ҷавонон ва нигоҳубини пӯсти рӯй онҳо дар зимистон
Бо фарорасии фасли зимистон пӯсти инсон ба якчанд мушкилӣ рӯ ба рӯ мешавад. Якум, вазидани шамоли сард дар кӯча. Дуюм, ... -
Туберкулёз: Главное, что нужно о нем знать
Даже в наше время, в XXI веке, заболевание туберкулезом все еще остается одной из наиболее «популярных» инфекционных болезней в мире. ... -
Донишҷӯён ба кӯҳҳо мераванд: гиёҳдӯстонро чӣ гуна тарбия мекунанд?
Донишҷӯёни Коллеҷи ҷумҳуриявии тиббии шаҳри Душанбе ҳар тобистон ба кӯҳҳо рафта, ба боло мебароянд ва дар он ҷо растаниҳои шифобахш ... -
Диагностика туберкулеза
Чтобы качественно провести диагностику активного легочного туберкулеза, специалист в первую очередь изучает историю болезни пациента, проводит его физическое обследование. Диагностика ... -
Чаро ҷавонони мо фаромӯшхотир шудаанд?
Тарс, асабоният, серкорӣ, фишороварӣ ва чанд амалҳои дигаре ҳастанд, ки дар зиндагии ҳаррӯзаи одамон вомехӯранд ва ба саломатии онҳо зарари ... -
Ҷавоне, ки ҳамнабзи сайёра аст!
Роҳи ягонаи амалӣ намудани мақсадҳои накӯ, пайдо намудани мавқеи худ дар ҷомеа ва саҳм гузоштан дар рушди кишвар маҳз тавассути ... -
Симптомы и формы туберкулеза
Туберкулез проявляется сначала общим недомоганием, повышенной температурой тела, головной болью. В результате процесса туберкулезной интоксикации (отравления организма продуктами жизнедеятельности бактерий) ... -
Ҷавонон саломатиашонро бояд муҳофизат намоянд
Донистани асосҳои гигиена, муҳофизати саломатии хеш ва зарар нарасонидан ба саломатии дигарон бояд сифати хуби ҳар як ҷавон бошад. Ин ...